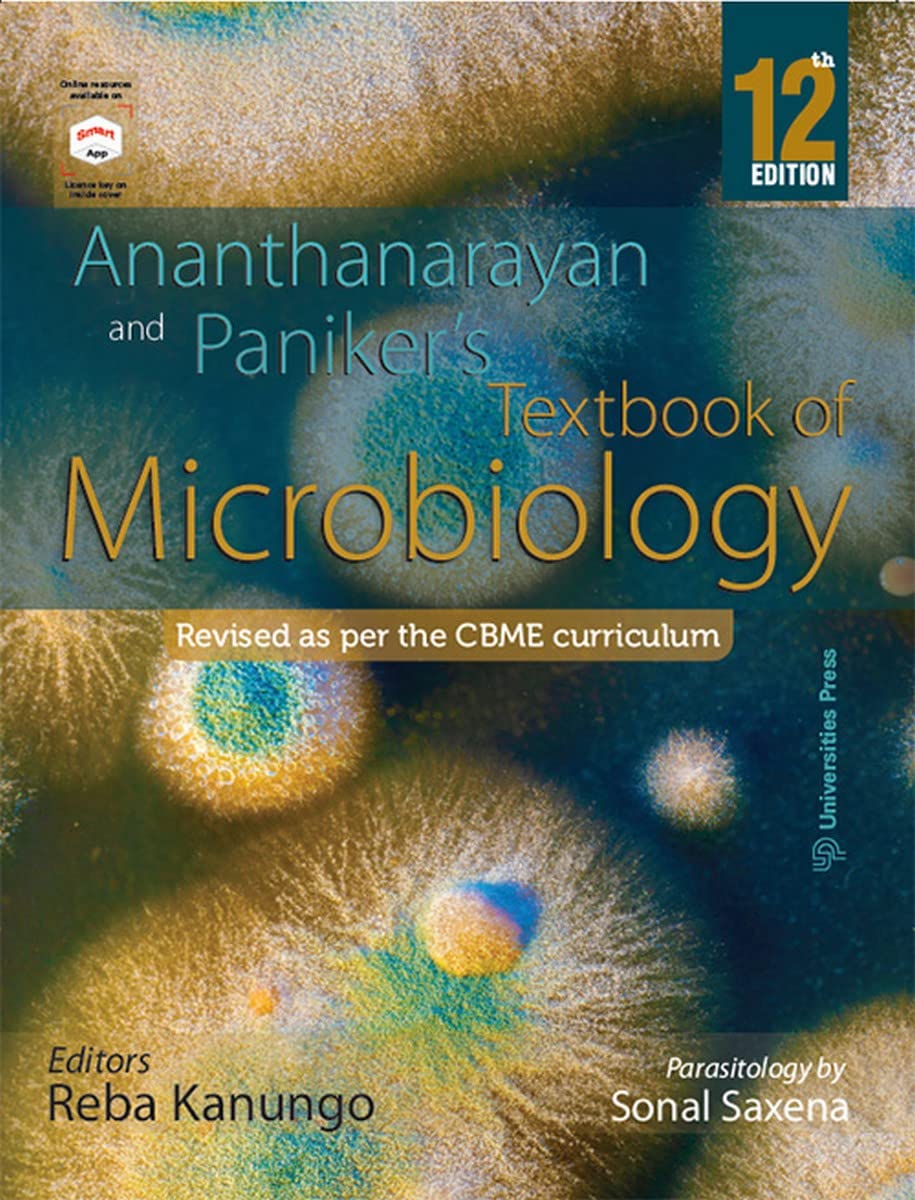
Ananthanarayan and Paniker’s Textbook of Microbiology, Twelfth Edition

Ananthanarayan and Paniker’s Textbook of Microbiology, Twelfth Edition
S**
Good
Nice
R**I
The Best Book on Microbiology for MBBS
Ananthanarayan and Paniker`s Textbook of Microbiology, 12th edition is the best book available for MBBS students. Written strictly as per the revised CBME syllabus prescribed by NMC makes it unique. The book is written keeping the students need in mind as per revised syllabus and teaching hours. A good nbumber of tables, flowcharts make it student friendly. Unneccesary content has been deleted keeping the focus on Undergraduates.Online resources ( Lecture slided, MCQs in asseement form, cases) given on the OBS smart app and website of the publisher are very hepful for students to prepare for examination.A perfect package for students.
D**A
शानदार किताब
Like awesome book
The best of medical microbiology 👍
S**M
Not so good
Apurv is better. This is a nightmare to read
T**A
THE best book for Microbiology MBBS
The following points make this book the best book for microbiology MBBS students:* New diagrams* CBME based* Interactive and easily readable tables* Important points have been highlighted* Easy to replicate, schematic diagram* Easy to understand language* One of the Best immunology content there is* Systematic topics* Flow charts* One stop for micro* Good quality images
A**
Revised 12th edition 2022 is perfect for MBBS students
This 12th edition of classic Ananthnarayan Microbiology is revised as per CBME curriculum and integrated PARASITOLOGY in the book itself. Also many more features provided in App like MCQs chapter wise Case studies etc..freely. I strongly recommend this Revised 12th edition for MBBS students.
Trustpilot
2 weeks ago
5 days ago